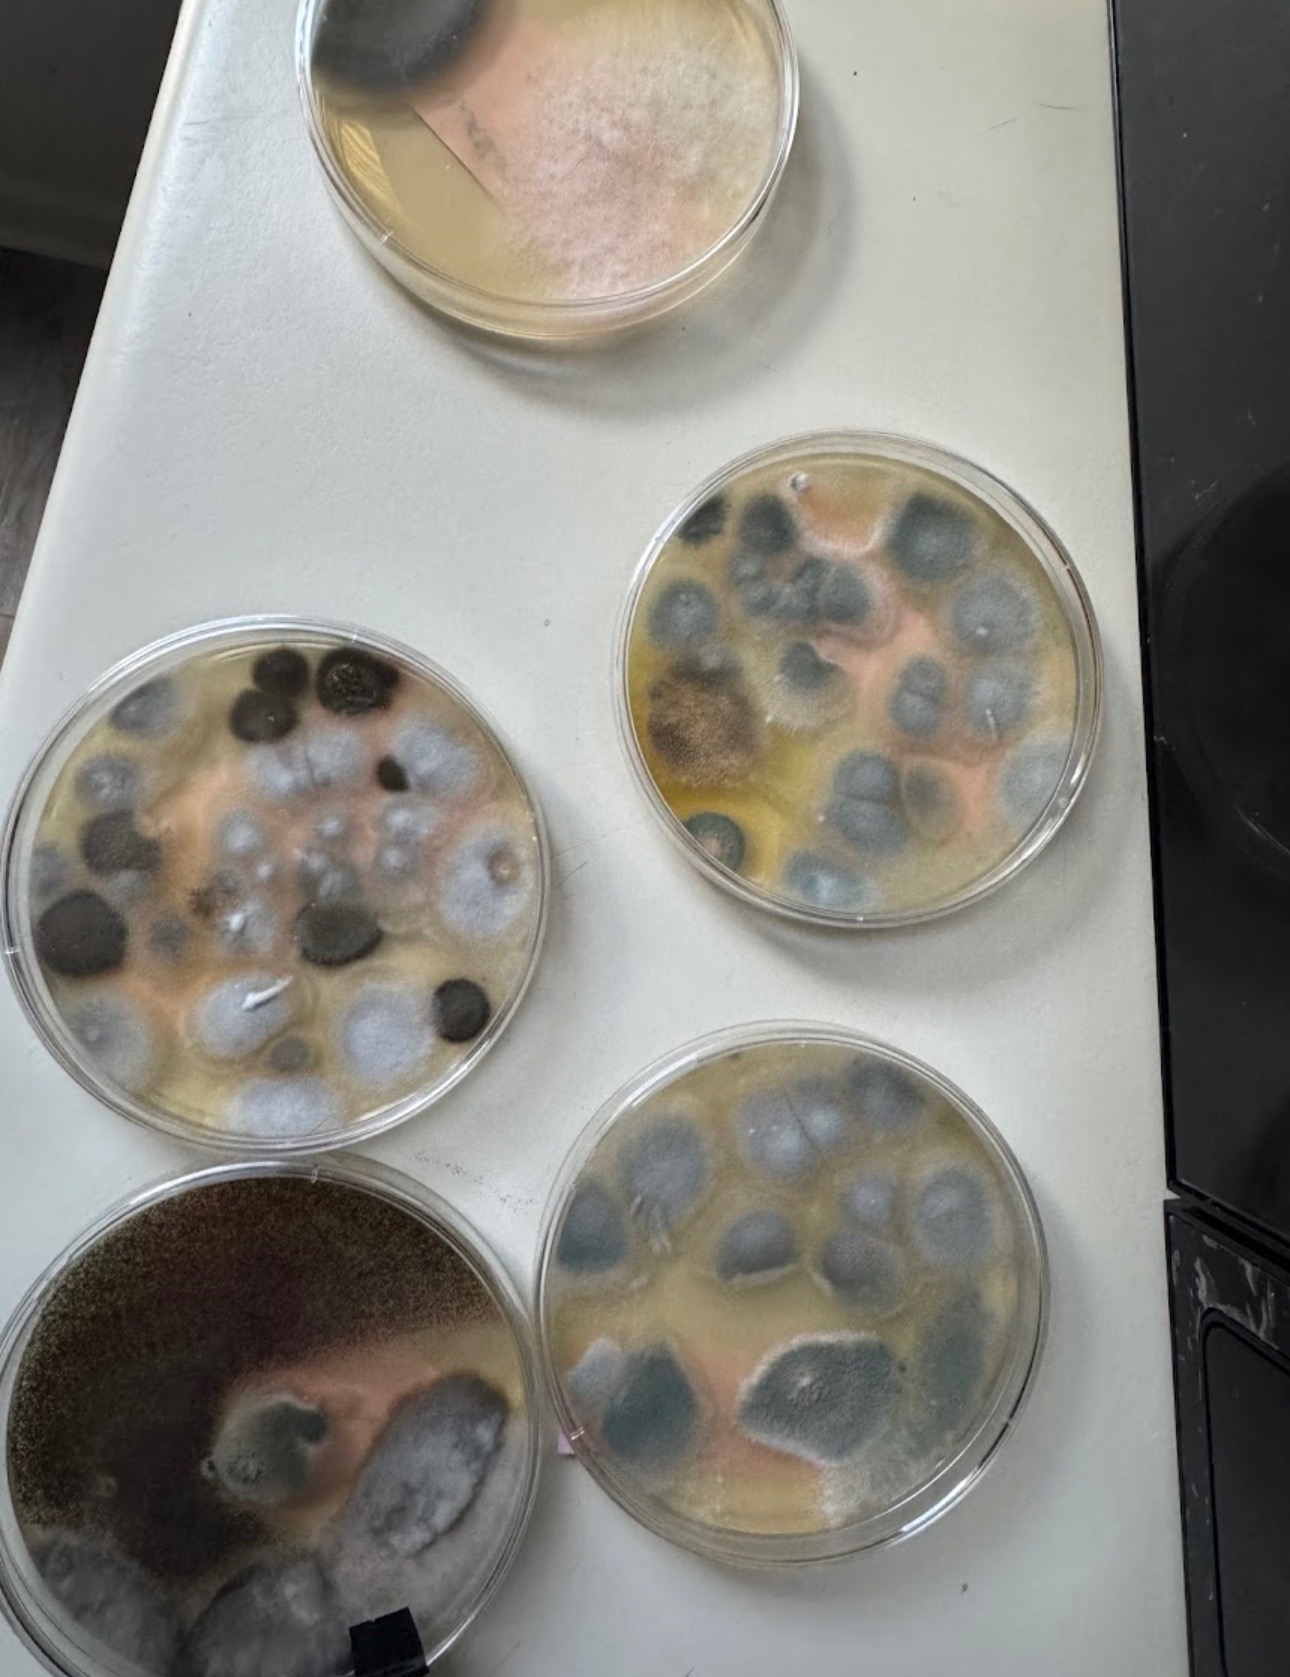
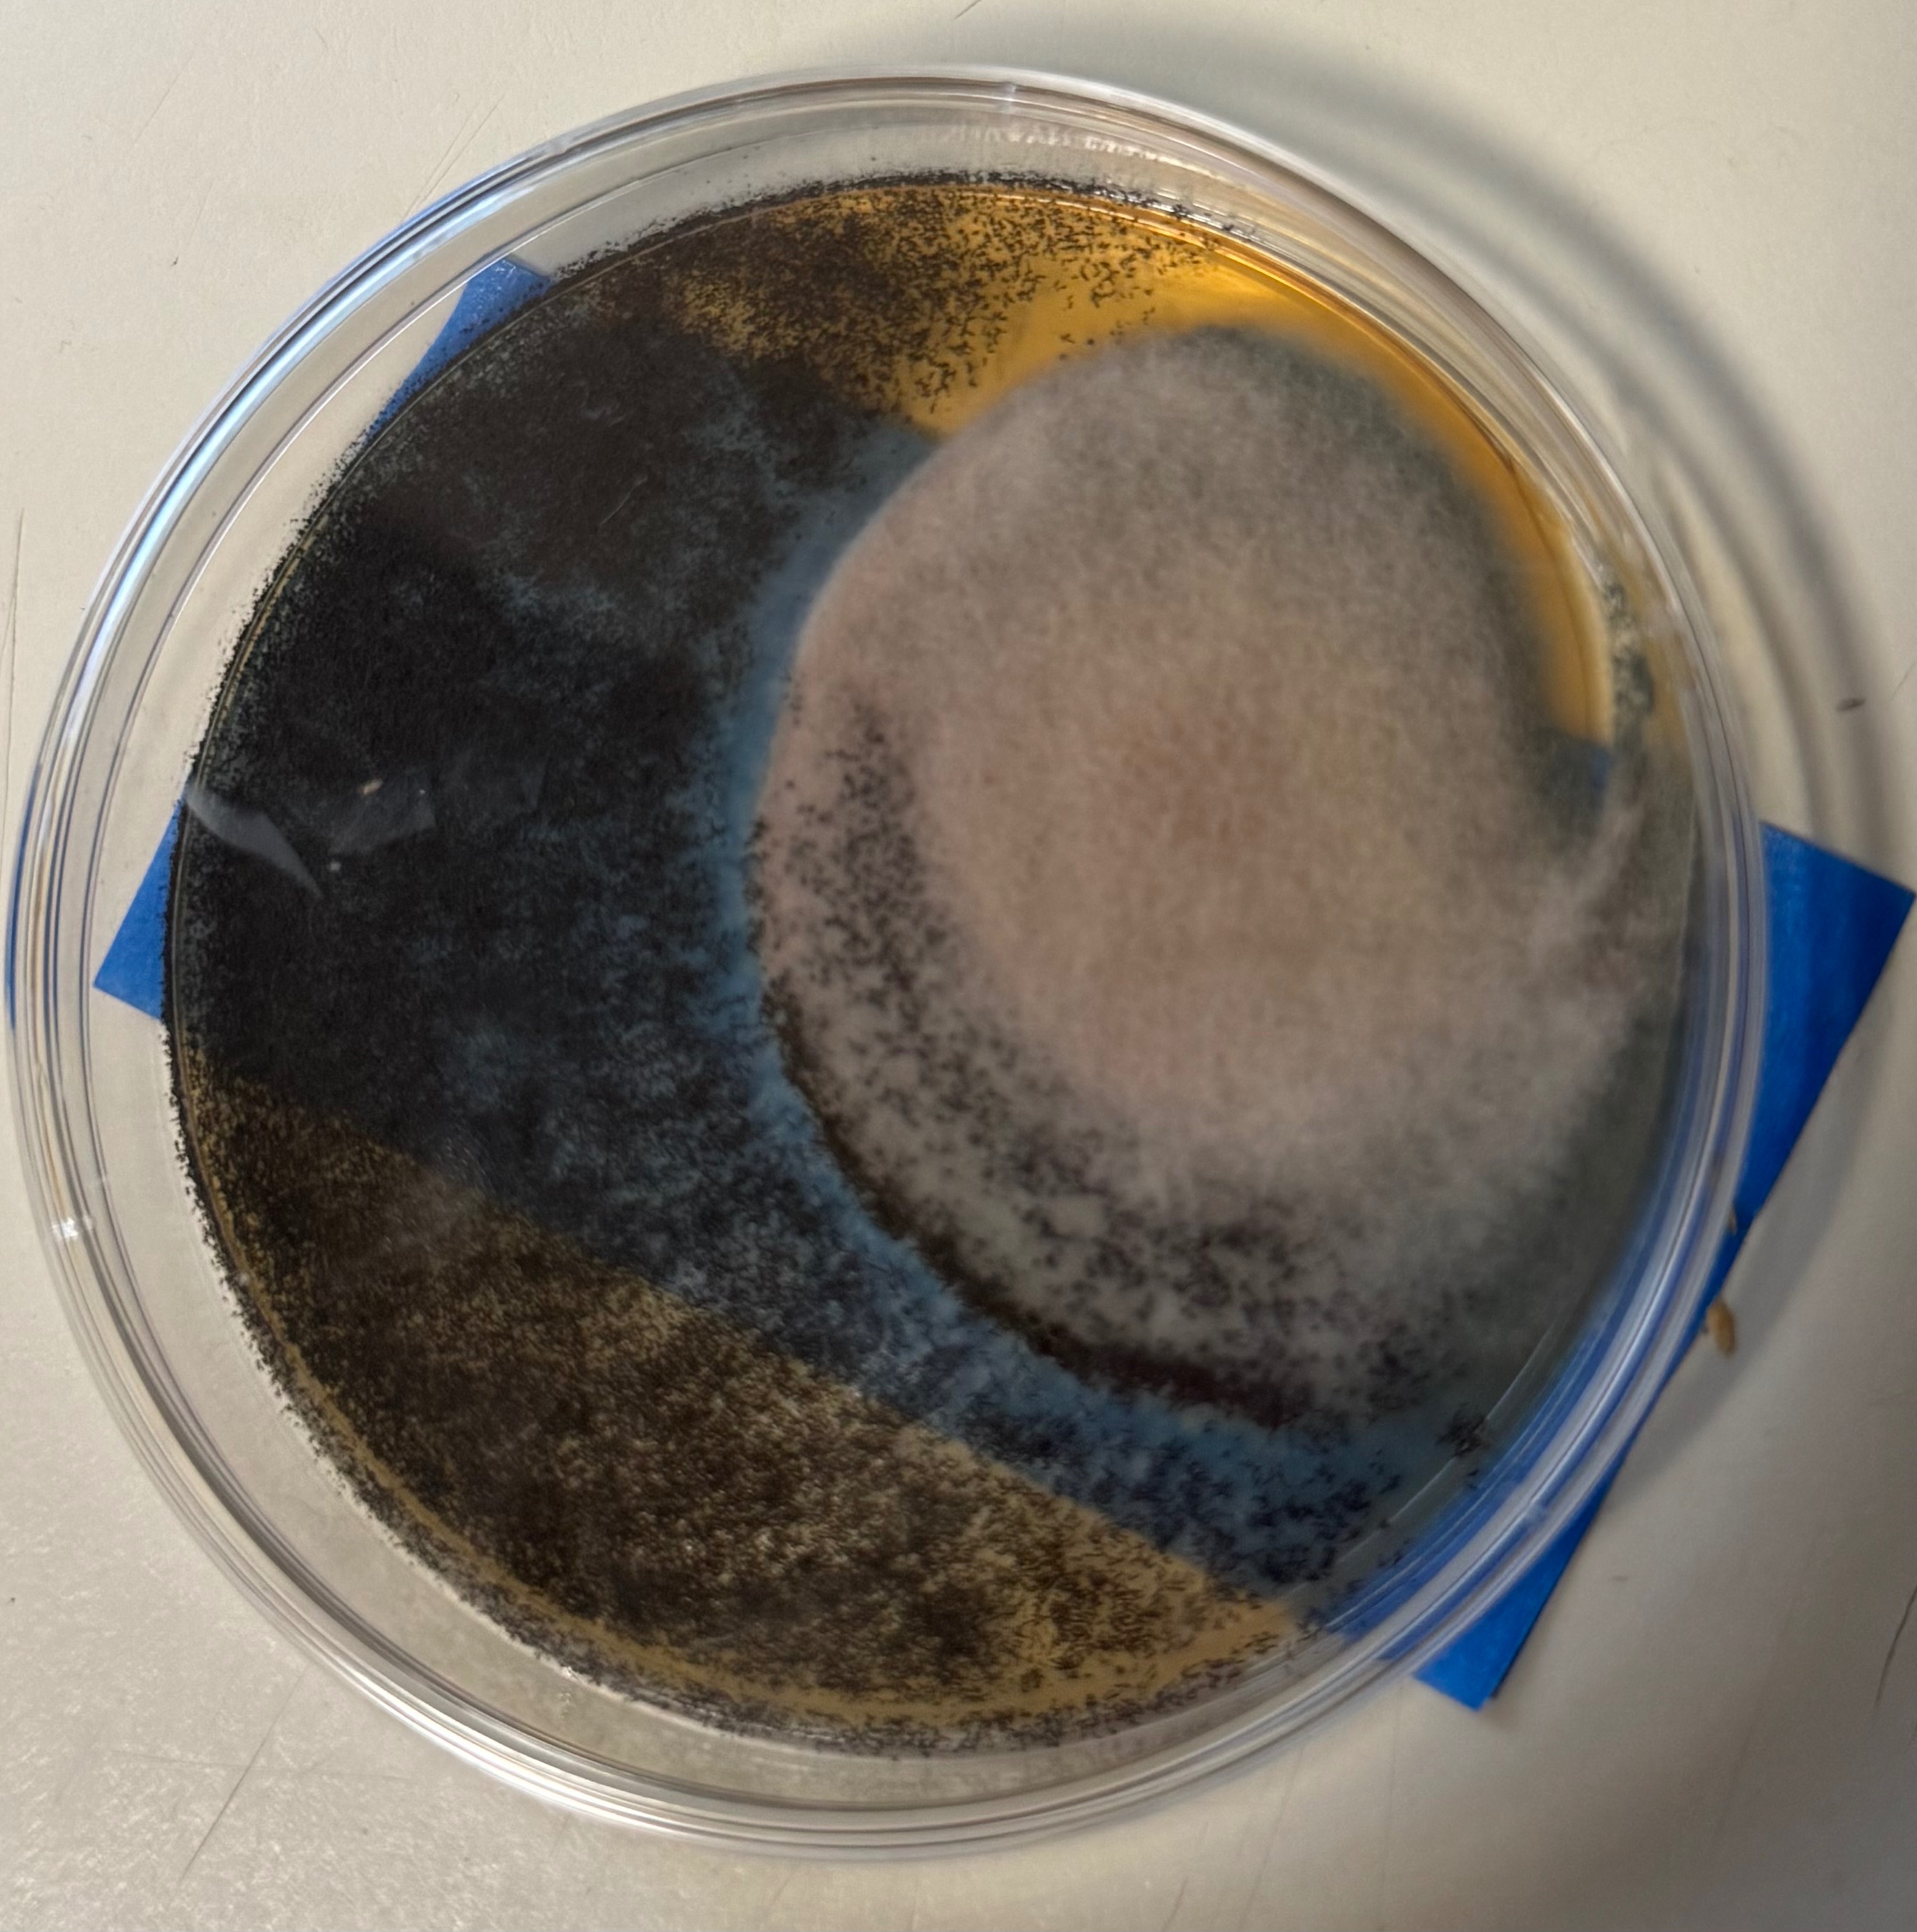

- M
Hi, my name is Kimora. I’m reaching out for support as I navigate a difficult transition balancing my health, my mental health, my ESAs (cats) wellbeing, and a housing challenge that has deeply impacted my stability.
Since moving into my apartment early 2024, both I and my two cats, Pandora and Casper, developed respiratory issues and allergy-like symptoms that were traced to mold and poor air quality in the unit. Despite documenting everything and communicating clearly with management, the issues persisted, affecting my ability to work and maintain consistent income.
I’ve since been diagnosed with asthma and was recently hospitalized after a severe flare-up that was unresponsive to my inhaler. Bills, missed work, and continued exposure to the apartment’s conditions created a chain reaction that made it difficult to keep up with rent. Instead of compassion or collaboration, management initiated eviction proceedings — even after I submitted proof, made partial payments, and requested a lease termination without penalty.
Now I’m not only trying to recover physically, but I’m also dealing with the financial burden of attorney fees and court costs to appeal the eviction, all while keeping my health stable and ensuring my cats have a safe place to live.
Your donations will go directly toward:
• Securing new, safe housing for me and my cats
• Covering medical and medication expenses for my asthma recovery and any vet bills my babies need
• Paying attorney and court fees related to my ongoing appeal
• Catching up on essential bills while I rebuild
I’ve always tried to handle things independently and stay strong, but this situation has tested me in every way and I don’t know where else to turn and going back home is not ideal. Any support, whether through donations or simply sharing this page, will help me create stability and move forward with peace and dignity.
Thank you for seeing me, for caring, and for helping me breathe a little easier again. Every penny is appreciated.
Check my apartment review at: Luna Pointe Apartments Hampton VA 23666 for credibility